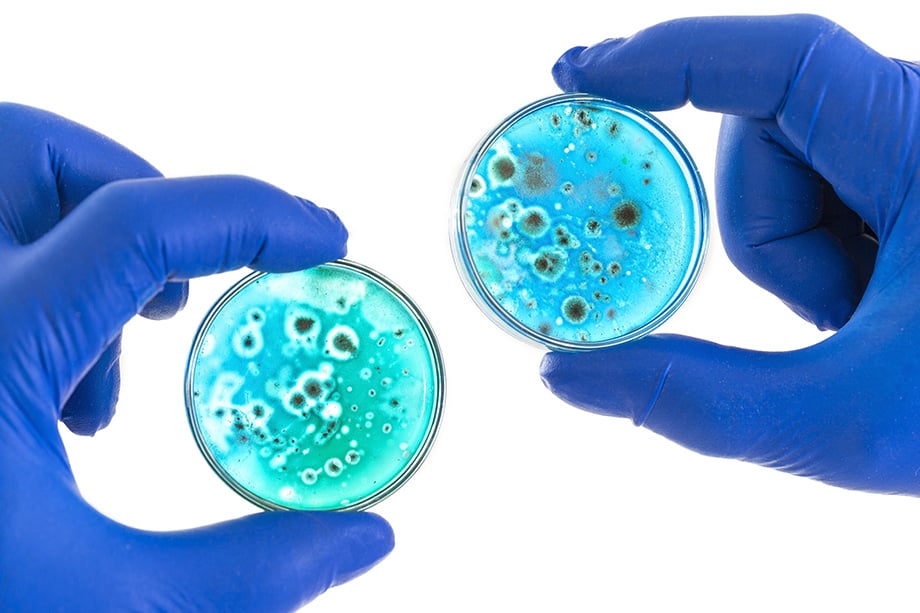

Specialist Biotechnology Translation Services
The biotechnical and medical industries are growing at an unprecedented rate. With that growth comes an increasing number of drug inserts, clinical trial materials, specifications, regulatory documents, patents, technical datasheets, scientific papers, quality assurance documents, and more. These safety-vital documents need to be translated with absolute accuracy so that they may be distributed worldwide. Therefore, biotechnology translation services are in high demand. Whether it be relating to private or public biotechnology or healthcare, we can handle your project from start to finish. With translators for over 200 different languages, you can ensure that medicines and documentation can safely get to wherever they’re required in the world. With twenty years in the industry, our certified biotechnology translation services have been used over the years by a wide range of clients, including GSK, the NHS, the GMC (General Medical Council), and more.